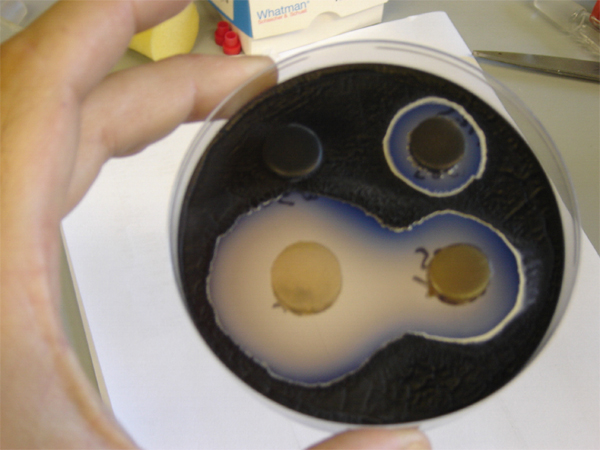

Our Research
Chemistry and biology of natural products
Lona Alkhalaf is Assistant Professor in the Department of Chemistry at the University of Warwick, UK. She uses organic chemistry, enzymology and X-ray crystallography to investigate the function, structure and mechanism of enzymatic targets of natural products and of enzymes involved in natural product production, including polyketide synthases, non-ribosomal peptide synthetases, and post assembly line tailoring enzymes.
Structure and function of RNA viruses
| My group studies processes performed by negative sense RNA viruses that infect humans and animals. Each year viruses from these families cause localised epidemics and rare global pandemics. We study members of the influenza virus, hantavirus, nairovirus, and bornavirus families. Much of our research focuses on how these viruses use a virally encoded protein called the polymerase to replicate and transcribe their viral genome. |
Structural molecular biology of clathrin-mediated endocytosis
Clathrin-mediated endocytosis operates through formation of a vesicle from the cell's membrane trapping cargo molecules inside. This process is controlled by a network of proteins which include clathrin and a set of adaptor proteins which bind to clathrin. Clathrin assembles to form a polyhedral cage which, together with its adaptor proteins, forms a coat around the vesicle. The vesicles then detach from the membrane and move to a location inside the cell to deliver their contents. It remains a mystery how so many different adaptor proteins coordinate with a single protein so that this cellular postal system can achieve its function.
Iron metabolism in brain disorders
We are interested in the role of iron metabolism in brain disorders, and has contributed to developments in synchrotron spectromicroscopy analysis of metals in human tissues, and in magnetic resonance imaging of iron levels in tissue samples, to inform clinical measurement of iron dysregulation in neurodegenerative disorders. Correlative imaging is increasingly a focus in our laboratory, including methods to enable label free microscopy of organic and inorganic tissue components.
Analytical theory of membrane geometry and dynamics
| The Turner group work on analytic theories describing the geometry and dynamics of membranes in the presence of embedded or associated membrane proteins. |
Structure and mechanism of transporters
Recent research on transporters in my group has focussed on sodium-coupled secondary transporters belonging to two different classes: the Bile Acid Sodium Symport (BASS) family and the Nucleobase Cation Symporter 1 (NCS1) family. Through X-ray crystallography coupled with biophysical assays (stability assays, isothermal titration calorimetry, microscale thermophoresis), biochemical experiments (radio-labelled transport assays) and site-directed mutagenesis, we are beginning to understand the varying effects of binding of small molecules and ions on the conformational states of these different classes of transporter.
Novel diffractive imaging techniques
| My research has been focused primarily on developing novel computational diffractive imaging techniques (ptychography, 4D STEM) for cryogenic electron microscopy (Cryo-EM), liquid EM, light atomic detecting (O, Li elements), low dose imaging (beam sensitive materials), 3D reconstruction and EM field mapping, which can then tackle characterization challenges across the physical and life sciences, ranging from pharmaceutical materials to biological macromolecules. |
Molecular dynamics of membrane proteins
| We use computational methods, in particular molecular dynamics (MD) simulations, to study membrane proteins. Our primary focus is on enzymes and transport systems in the cell envelope of pathogenic bacteria, with the aim of understanding and controlling drug-resistant infections. |
Structure and microbiology of bacterial cell division
| The Crow lab use structural and microbiological techniques to understand how bacteria divide, defend themselves from antibiotics and secrete protein toxins.We are especially interested in novel Type VII ABC transporter systems located in the bacterial cell envelope. |
Structure and mechanism of the plant hormone auxin
| Our primary interest is in how the plant hormone auxin works because its actions are the foundations for most of the green plant world. As biochemists, we are fascinated by how specificity is conferred for auxin. Millions of similar, but different small organic molecules cause no reaction at all, whilst the natural hormone molecule (indole-3-acetic acid, IAA) fits into its binding pocket perfectly and in doing so activates the plant world. |
Biophysical principles of bacterial cell wall biosynthesis
| My lab studies biophysical principles of bacterial cell wall biosynthesis, with a particular focus on the protein complexes that perform bacterial cell division and elongation. We work primarily with the Gram-positive model organism Bacillus subtilis. Core techniques are in vivo studies of single molecule dynamics in living cells by single molecule tracking and super-resolution microscopy, and in vitro studies of protein structural dynamics by single molecule FRET. |
Growth of cell walls in pathogenic bacteria
| Research in my group is focused on the way in which pathogenic bacteria make their cell walls grow, how that is related to the ways in which they divide and reproduce and also the relationship of these processes to the discovery and resistance to antibiotics. |
Structure and function of proteins involved in zinc homeostasis
|
Using mass spectrometry to investigate enzymes involved in natural product synthesis
| Research in the Jenner lab focuses on the application of mass spectrometry, in combination with other analytical and structural techniques, to solve complex biological problems. Our primary interest concerns the enzymes involved in natural product biosynthesis. |
Molecular dialogue between plants and pathogens
| Research in the Grant lab focusses on the molecular dialogue between plants and pathogens and how plant disease resistosomes are modified by small molecules |
Mechanistic enzymology of cell wall biosynthesis
| The Dowson lab are interested in mechanistic enzymology of validated and novel drug targets involved in cell wall biosynthesis and protein biosynthesis to inform biology and drug discovery. |
Methods for describing the assembly, structure and interactions of membrane proteins and membrane-active peptides
| The Dixon group aims to develop methods for describing the assembly, interactions and three-dimensional structures of membrane proteins -particularly membrane proteins associated with immune receptors such as the major histocompatibility complex (MHC) and the B-cell receptor (BCR). I am also interested in understanding and exploring the wide functionality of membrane-active helical peptides such as membrane curvature sensors and membrane-lytic antimicrobial peptides. |
Application of mass spectrometry instrument development to complex biochemical problems |
Understanding and exploiting control of production of bioactive molecules
| Our research group is particularly interested in understanding and exploiting the regulatory mechanisms that control the production of bioactive molecules (e.g. antibiotics, agrochemicals, sunscreen agent) in actinobacteria. |
Understanding the mechanism of bacterial cell envelope biosynthesis
| Our research focuses on the structural biology of the Gram-negative bacterial cell envelope that is a critical barrier contributing to antimicrobial resistance. We investigate how protein complexes assemble, and function synergistically to construct and maintain this intricate three-layered envelope. Employing an interdisciplinary approach, we integrate cryo-electron microscopy with protein biochemistry, microbiology, and fluorescence microscopy to elucidate the mechanisms underpinning envelope biogenesis. |
Bioactive discovery through mass spectrometry and NMR
|